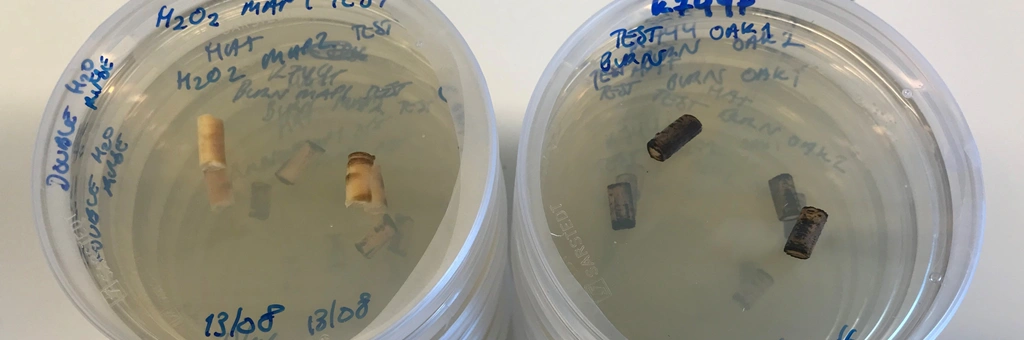

Endofyttisk sopp i trær
23-19
Boreprøver med endofytisk sopp kultiveres i laboratorium.
Endofyttisk sopp lever inne i trær, men er ofte harmløse for vertstreet. Disse kan være vanskelige å finne og identifisere, så nå skal gruppene kulesekksopper (Eurotiomycetes) og tykksekksopper (Dothideomycetes) i edelløvtrær studeres nærmere.
- Innhold
- Nyhetssak
- Resultater
Sommereik, bøk, lind og spisslønn er kjent for å være voksested for mange sopparter, og dette prosjektet skal kartlegge diversiteten av de dårlig kjente soppgruppene kulesekksopper og tykksekksopper som begge er i rekken sekksporesopper (Ascomycota). Sannsynligvis er det i disse gruppene mange ukjente arter, fordi de er vanskelige å få øye på eller vokser på helt spesielle steder.
Prosjektet skal samle inn kvister, samt undersøke barken og veden ved å ta boreprøver. Både kvistene, barken og veden vil deretter bli DNA-sekvensert, slik at man kan anslå mangfoldet av sopparter som er til stede i treet. DNA-sekvenseringen i kombinasjon med kultivering av sopp fra trærne vil bli brukt til å identifisere spesifikke arter. Det forventes å finne nye arter både for Norge og for vitenskapen. Det har tidligere vært liten fokus på å studere enkeltarter, så et av prosjektet sine mål vil være å navngi så mange taksa som mulig.
Resultater
Hovedmålet med prosjektet var å øke kunnskapen om endofyttiske sopp knyttet til levende stammer og kvister av bøk, eik, lind og lønn i Norge. Totalt ble det boret 208 trær og det ble tatt splintvedprøver for metabarcoding. Prosjektet identifiserte 62 nye Ascomycota-arter for Norge. Prøvetaking av ascomata fra stammer og kvister av de borede trærne ga ytterligere to nye arter for Norge, inkludert én ubeskrevet art. Prøvetaking fra flere trær (andre treslag) under vårt feltarbeid ga to ubeskrevne slekter og flere ubeskrevne arter (beskrivelser pågår).
Kontrollert for prøvestørrelse hadde eik betydelig høyere artstetthet av endofyttisk sopp enn spisslønn, bøk og lind. Sammenliknet med eik hadde bøk 21%, lønn hadde 14.9% og lindetrærne hadde 14.5%. Det var ingen effekt av hverken trestørrelse eller region på artstettheten for de ulike treartene. På eik var de vanligste artene Riflesprekksopp Hysterium pulicare og Navicella pileata, men de fant også arter som Rebentischia unicaudata og Zignoëlla fallax. Det mest interessante funnet var en ubesrevet art av Nigrograna, som nå dyrkes. På bøk var Bøkebarkleppe Ascodichaena rugosa dominerende, og lite annet ble funnet. På ett eneste lønnetre ble det funnet Decaisnella mesascium. Lindetrærne var så å si fri for ascomata. Det eneste som ble funnet på lindetrærne var Arthopyrenia platypyrenia.








